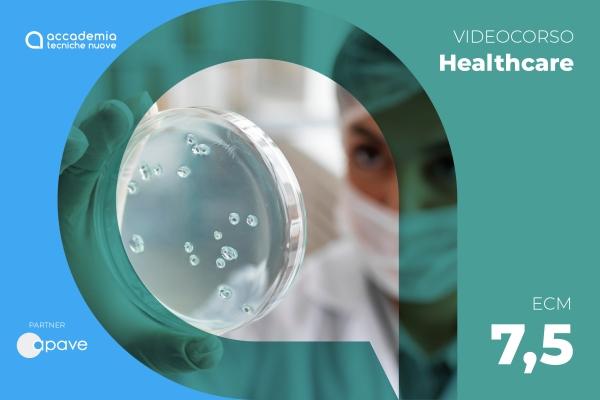

Negli ultimi trent’anni il numero di casi di legionellosi in Italia è aumentato costantemente, sebbene la legionellosi sia una malattia ampiamente sottostimata.
Nel 2022 sono stati notificati all’ISS complessivamente 3.111 casi di legionellosi, con un incremento del 14% rispetto all'anno precedente; il numero di casi segnalati è quindi tornato, dopo due anni, ai valori pre-pandemici. Dei 3.111 casi di legionellosi, 3.039 sono stati classificati come casi confermati e 72 come casi probabili. Il 77% dei casi è stato notificato da 6 Regioni: Lombardia, Emilia-Romagna, Toscana, Veneto, Lazio e Piemonte e il restante 23% dalle rimanenti 15 Regioni e Province Autonome. (Dati Epicentro 2022).
Nell’autunno del 2024 ci sono stati diversi focolai nella provincia di Milano mettendo in evidenza la necessità per tutti i professionisti sanitari e none per i cittadini di conoscere quale e il rischio microbiologico legato alla legionella e le principali precauzioni per evitare lo sviluppo della patologia correlata.
Quindi la Legionella non rappresenta solo un rischio per le strutture sanitarie, ma anche per la salute pubblica, in quanto i focolai possono estendersi oltre l'ambiente ospedaliero. Conoscere la Legionella aiuta i professionisti sanitari e non a partecipare attivamente a indagini e a risposte rapide in caso di epidemie, proteggendo la salute della comunità.
Il video corso è stato realizzato con lo scopo di fornire le conoscenze fondamentali sul rischio microbiologico legato alla Legionella, con un approfondimento su prevenzione, identificazione e gestione dei rischi negli ambienti lavorativi.